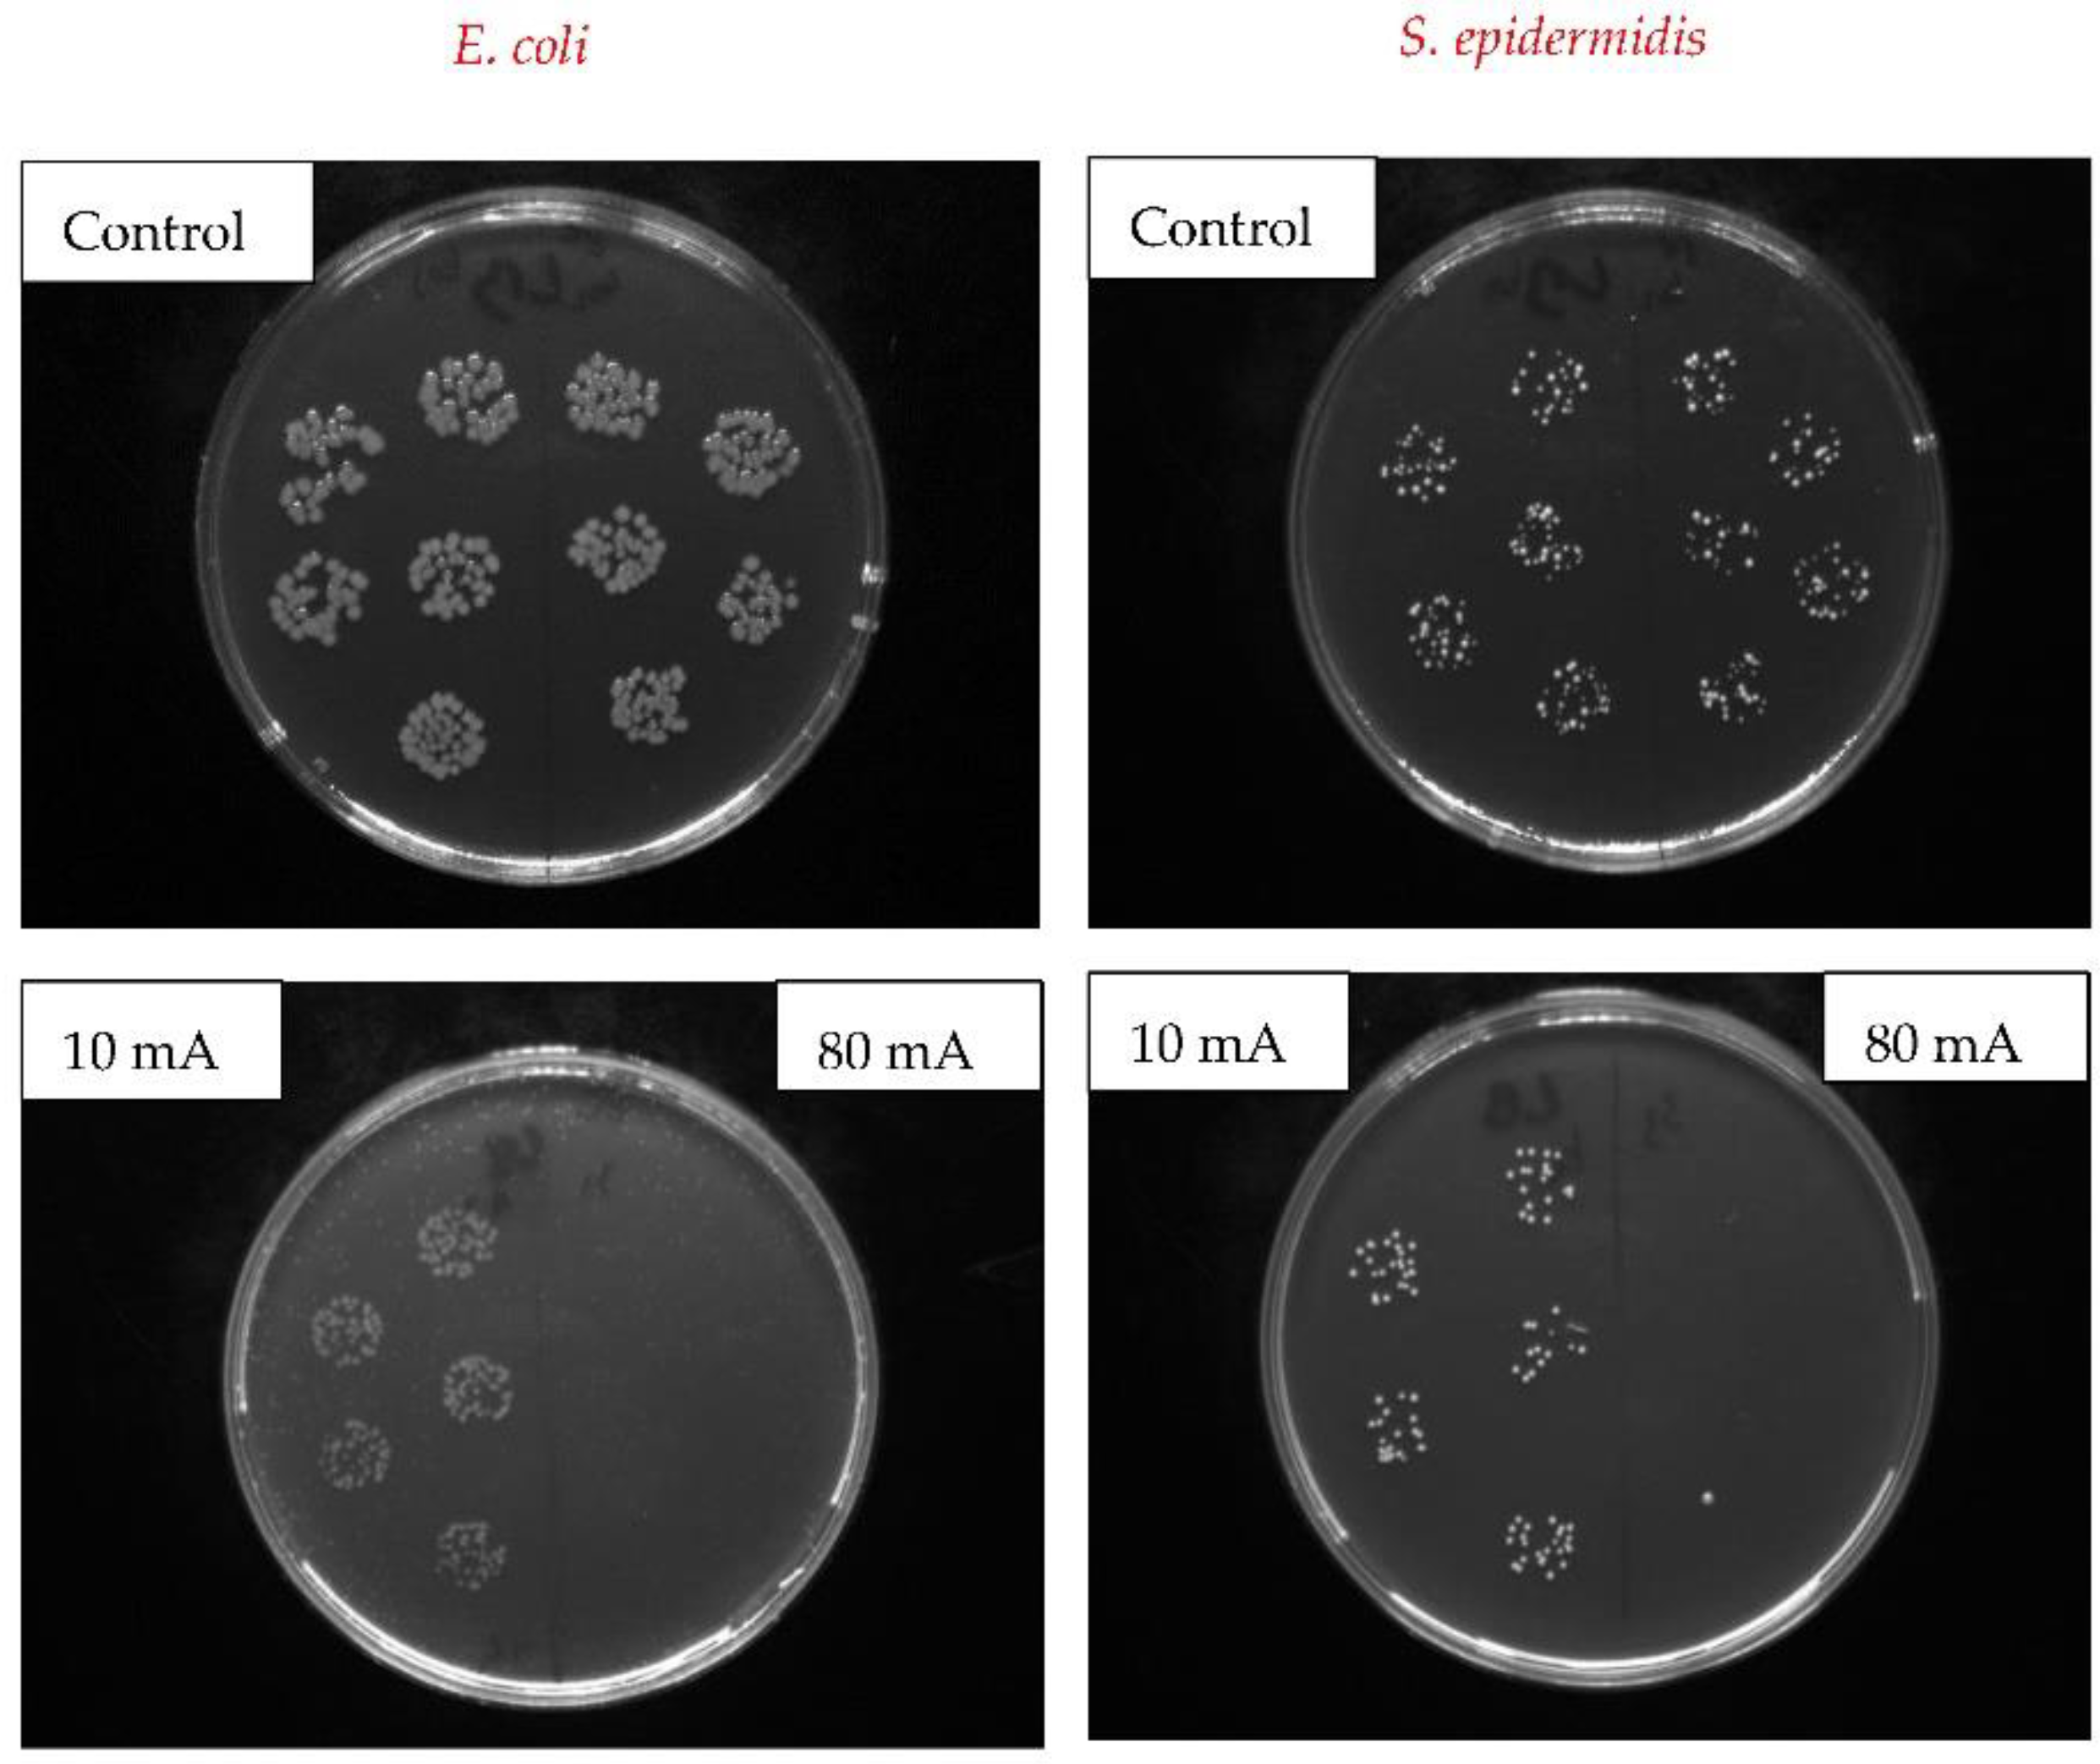
Nanomaterials 12 02658 g010

Antibacterial Properties of Silver Nanoclusters with Carbon Support on Flexible Polymer
Abstract
:1. Introduction
2. Materials and Methods
2.1. Materials
2.2. Analytical Methods
2.3. Antibacterial Tests
3. Results
3.1. Surface Morphology: AFM and SEM Methods
3.2. Surface Chemistry Analysis
3.3. Optical Properties
3.4. Antibacterial Properties
4. Conclusions
Author Contributions
Funding
Institutional Review Board Statement
Informed Consent Statement
Data Availability Statement
Conflicts of Interest
References
- Olayil, R.; Arumugaprabu, V.; Das, O.; Lenin Anselm, W.A. A Brief Review on Effect of Nano fillers on Performance of Composites. IOP Conf. Ser. Mater. Sci. Eng. 2021, 1059, 012006. [Google Scholar] [CrossRef]
- Kvítek, O.; Kopáček, V.; Řezníčková, A.; Švorčík, V. Detection of organic vapors on sputtered and annealed thin Au film. J. Phys. Conf. Ser. 2018, 985, 012005. [Google Scholar] [CrossRef] [Green Version]
- Crosby, A.J.; Lee, J.Y. Polymer Nanocomposites: The “Nano” Effect on Mechanical Properties. Polym. Rev. 2007, 47, 217–229. [Google Scholar] [CrossRef]
- Alexandre, M.; Dubois, P. Polymer-layered silicate nanocomposites: Preparation, properties and uses of a new class of materials. Mater. Sci. Eng. R Rep. 2000, 28, 1–63. [Google Scholar] [CrossRef]
- Mousavi, S.R.; Estaji, S.; Kiaei, H.; Mansourian-Tabaei, M.; Nouranian, S.; Jafari, S.H.; Ruckdaschel, H.; Arjmand, M.; Khonakda, H.A. A review of electrical and thermal conductivities of epoxy resin systems reinforced with carbon nanotubes and graphene-based nanoparticles. Polym. Test. 2022, 112, 107645. [Google Scholar] [CrossRef]
- Geim, A.K.; Novoselov, K.S. The rise of graphene. Nat. Mater 2007, 6, 183–191. [Google Scholar] [CrossRef]
- Novoselov, K.S.; Geim, A.K.; Morozov, S.V.; Jiang, D.; Zhang, Y.; Dubonos, S.V.; Grigorieva, I.V.; Firsov, A.A. Electric Field Effect in Atomically Thin Carbon Films. Science 2004, 306, 666. [Google Scholar] [CrossRef] [Green Version]
- Al Sheheri, S.Z.; Al-Amshany, Z.M.; Al Sulami, Q.A.; Tashkandi, N.Y.; Hussein, M.A.; El-Shishtawy, R.M. The preparation of carbon nanofillers and their role on the performance of variable polymer nanocomposites. Des. Monomers Polym. 2019, 22, 8–53. [Google Scholar] [CrossRef] [Green Version]
- Zhang, F.; Yang, K.; Liu, G.; Chen, Y.; Wang, M.; Li, S.; Li, R. Recent advances on graphene: Synthesis, properties and applications. Compos. Part A 2022, 160, 107051. [Google Scholar] [CrossRef]
- Wei, J.; Atif, R.; Vo, T.; Inam, F. Graphene Nanoplatelets in Epoxy System: Dispersion, Reaggregation, and Mechanical Properties of Nanocomposites. J. Nanomater. 2015, 2015, 561742. [Google Scholar] [CrossRef] [Green Version]
- Esfandiari, M.; Lalbakhsh, A.; Shehni, P.N.; Jarchi, S.; Ghaffari-Miab, M.; Mahtaj, H.N.; Reisenfeld, S.; Alibakhshikenari, M.; Koziel, S.; Szczepanski, S. Recent and emerging applications of Graphene-based metamaterials in electromagnetics. Mater. Des. 2022, 221, 110920. [Google Scholar] [CrossRef]
- Yavari, F.; Koratkar, N. Graphene-Based Chemical Sensors. J. Phys. Chem. Lett. 2012, 3, 1746–1753. [Google Scholar] [CrossRef] [PubMed]
- Šupová, M.; Martynková, G.S.; Barabaszová, K. Effect of nanofillers dispersion in polymer matrices: A review. Sci. Adv. Mater. 2011, 3, 1–25. [Google Scholar] [CrossRef]
- Rajak, D.K.; Pagar, D.D.; Menezes, P.L.; Linul, E. Fiber-Reinforced Polymer Composites: Manufacturing, Properties, and Applications. Polymers 2019, 11, 1667. [Google Scholar] [CrossRef] [PubMed] [Green Version]
- Szeluga, U.; Kumanek, B.; Trzebicka, B. Synergy in hybrid polymer/nanocarbon composites. A review. Compos. Part A Appl. Sci. Manuf. 2015, 73, 204–231. [Google Scholar] [CrossRef]
- Merino, C.A.I.; Ledezma Sillas, J.E.; Mezaa, J.M.; Herrera Ramirez, J.M. Metal matrix composites reinforced with carbon nanotubes by an alternative technique. J. Alloys Compd. 2017, 707, 257–263. [Google Scholar] [CrossRef]
- Shit, S.C.; Shah, P. A Review on Silicone Rubber. Natl. Acad. Sci. Lett. 2013, 36, 355–365. [Google Scholar] [CrossRef]
- Eduok, U.; Faye, O.; Szpunar, J. Recent developments and applications of protective silicone coatings: A review of PDMS functional materials. Prog. Org. Coat. 2017, 111, 124–163. [Google Scholar] [CrossRef]
- Li, X.; Gao, Z.; Li, B.; Zhang, X.; Li, Y.; Sun, J. Self-healing superhydrophobic conductive coatings for self-cleaning and humidity-insensitive hydrogen sensors. Chem. Eng. J. 2021, 410, 128353. [Google Scholar] [CrossRef]
- Razavi, M.; Primavera, R.; Vykunta, A.; Thakor, A.S. Silicone-based bioscaffolds for cellular therapies. Mater. Sci. Eng. C 2021, 119, 111615. [Google Scholar] [CrossRef]
- Pino, C.J.; Haselton, F.R.; Chang, M.S. Seeding of Corneal Wounds by Epithelial Cell Transfer from Micropatterned PDMS Contact Lenses. Cell Transplant. 2005, 14, 565–571. [Google Scholar] [CrossRef] [Green Version]
- Rus, D.; Tolley, M.T. Design, fabrication and control of soft robots. Nature 2015, 521, 467–475. [Google Scholar] [CrossRef] [PubMed] [Green Version]
- Burda, C.; Chen, X.; Narayanan, R.; El-Sayed, M.A. Chemistry and Properties of Nanocrystals of Different Shapes. Chem. Rev. 2005, 105, 1025–1102. [Google Scholar] [CrossRef]
- El-Sayed, M.A. Some Interesting Properties of Metals Confined in Time and Nanometer Space of Different Shapes. Acc. Chem. Res. 2001, 34, 257–264. [Google Scholar] [CrossRef]
- Sershen, S.R.; Westcott, S.L.; Halas, N.J.; West, J.L. Temperature-sensitive polymer–nanoshell composites for photothermally modulated drug delivery. J. Biomed. Mater. Res. 2000, 51, 293–298. [Google Scholar] [CrossRef] [Green Version]
- Cobley, C.M.; Chen, J.; Cho, E.C.; Wang, L.V.; Xia, Y. Gold nanostructures: A class of multifunctional materials for biomedical applications. Chem. Soc. Rev. 2011, 40, 44–56. [Google Scholar] [CrossRef] [Green Version]
- Qureshia, D.; Nayak, S.K.; Maji, S.; Anis, A.; Kim, D.; Pal, K. Environment sensitive hydrogels for drug delivery applications. Eur. Polym. J. 2019, 120, 109220. [Google Scholar] [CrossRef]
- McGillicuddy, E.; Murray, I.; Kavanagh, S.; Morrison, L.; Fogarty, A.; Cormican, M.; Dockery, P.; Prendergast, M.; Rowan, N.; Morris, D. Silver nanoparticles in the environment: Sources, detection and ecotoxicology. Sci. Total Environ. 2017, 575, 231–246. [Google Scholar] [CrossRef]
- Gherasim, O.; Puiu, R.A.; Bîrcă, A.C.; Burdușel, A.-C.; Grumezescu, A.M. An Updated Review on Silver Nanoparticles in Biomedicine. Nanomaterials 2020, 10, 2318. [Google Scholar] [CrossRef] [PubMed]
- Alonso, J.C.; Diamant, R.; Castillo, P.; Acosta–García, M.C.; Batina, N.; Haro-Poniatowski, E. Thin films of silver nanoparticles deposited in vacuum by pulsed laser ablation using a YAG:Nd laser. Appl. Surf. Sci. 2009, 255, 4933–4937. [Google Scholar] [CrossRef]
- Cao, C.; Zhang, T.; Yang, N.; Niu, X.; Zhou, Z.; Wang, J.; Yang, D.; Chen, P.; Zhong, L.; Dong, X.; et al. POD Nanozyme optimized by charge separation engineering for light/pH activated bacteria catalytic/photodynamic therapy. Signal Transduct. Target. Ther. 2022, 7, 86. [Google Scholar] [CrossRef]
- Kelly, P.J.; Arnell, R.D. Magnetron sputtering: A review of recent developments and applications. Vacuum 2000, 56, 159–172. [Google Scholar] [CrossRef]
- Chu, C.; Hu, X.; Yan, H.; Sun, Y. Surface functionalization of nanostructured Cu/Ag-deposited polypropylene fiber by magnetron sputtering. e-Polymers 2021, 21, 140–150. [Google Scholar] [CrossRef]
- Garrett, T.R.; Bhakoo, M.; Zhang, Z. Bacterial adhesion and biofilms on surfaces. Prog. Nat. Sci. 2008, 18, 1049–1056. [Google Scholar] [CrossRef]
- Song, F.; Koo, H.; Ren, D. Effects of Material Properties on Bacterial Adhesion and Biofilm Formation. J. Dent. Res. 2015, 94, 1027–1034. [Google Scholar] [CrossRef]
- Hu, H.; Burrow, M.F.; Leung, W.K. Evaluation of 12-hour in situ bacterial colonization on smooth restorative material surfaces. J. Dent. 2022, 119, 104071. [Google Scholar] [CrossRef]
- Mather, R.R. Surface modification of textiles by plasma treatments. In Surface Modification of Textiles, 1st ed.; Woodhead Publishing Limited: Shaston, UK, 2009; Chapter 13; pp. 269–317. [Google Scholar] [CrossRef]
- Hurtuková, K.; Fajstavrová, K.; Rimpelová, S.; Vokatá, B.; Fajstavr, D.; Slepičková Kasálková, N.; Siegel, J.; Švorčík, V.; Slepička, P. Antibacterial Properties of a Honeycomb-like Pattern with Cellulose Acetate and Silver Nanoparticles. Materials 2021, 14, 4051–4065. [Google Scholar] [CrossRef] [PubMed]
- Mafuné, F.; Kohno, J.-Y.; Takeda, Y.; Kondow, T.; Sawabe, H. Formation and Size Control of Silver Nanoparticles by Laser Ablation in Aqueous Solution. J. Phys. Chem. B 2000, 104, 9111–9117. [Google Scholar] [CrossRef]
- Philip, P.; Jose, T.; Philip, K.C.; Manoj, P.; Sajini, T. Studies on the hypsochromic shifted optical properties of gold nanoparticles embedded electrospun poly(methyl methacrylate) (PMMA) nanofibers. Mater. Today Proc. 2020, 33, 2174–2179. [Google Scholar] [CrossRef]
- Liu, X.; Li, D.; Sun, X.; Li, Z.; Song, H.; Jiang, H.; Chen, Y. Tunable Dipole Surface Plasmon Resonances of Silver Nanoparticles by Cladding Dielectric Layers. Sci. Rep. 2015, 5, 12555. [Google Scholar] [CrossRef] [PubMed] [Green Version]
- Shivashankar, H.; Kevin, A.M.; Manohar, S.B.S.; Kulkarni, S.M. Investigation on dielectric properties of PDMS based nanocomposites. Phys. B Condens. Matter 2021, 602, 412357. [Google Scholar] [CrossRef]
- Ferreira, T.P.M.; Nepomuceno, N.C.; Medeiros, E.L.G.; Medeiros, E.S.; Sampaio, F.C.; Oliveira, J.E.; Oliveira, M.P.; Galvão, L.S.; Bulhões, E.O.; Santos, A.S.F. Antimicrobial coatings based on poly(dimethyl siloxane) and silver nanoparticles by solution blow spraying. Prog. Org. Coat. 2019, 133, 19–26. [Google Scholar] [CrossRef]
- Slepička, P.; Hurtuková, K.; Fajstavr, D.; Slepičková Kasálková, N.; Lyutakov, O.; Švorčík, V. Carbon-gold nanocomposite induced by unique high energy laser single-shot annealing. Mater. Lett. 2021, 301, 130256. [Google Scholar] [CrossRef]
- Jing, Y.; Wang, R.; Wang., Q.; Xiang, Z.; Li, Z.; Gu, H.; Wang, X. An overview of surface-enhanced Raman scattering substrates by pulsed laser deposition technique: Fundamentals and applications. Adv. Compos. Hybrid Mater. 2021, 4, 885–905. [Google Scholar] [CrossRef] [PubMed]
- Kima, J.H.; Twaddle, K.M.; Cermak, L.M.; Jang, W.; Yun, J.; Byun, H. Photothermal heating property of gold nanoparticle loaded substratesand their SERS response. Colloids Surf. A Physicochem. Eng. Asp. 2016, 498, 20–29. [Google Scholar] [CrossRef]
- Slepičková Kasálková, N.; Slepička, P.; Švorčík, V. Carbon Nanostructures, Nanolayers, and Their Composites. Nanomaterials 2021, 11, 2368–2391. [Google Scholar] [CrossRef] [PubMed]
- Lišková, J.; Slepičková Kasálková, N.; Slepička, P.; Švorčík, V.; Bačáková, L. Heat-treated carbon coatings on poly (L-lactide) foils for tissue engineering. Mater. Sci. Eng. C 2019, 100, 117–128. [Google Scholar] [CrossRef]
- Slepicka, P.; Siegel, J.; Lyutakov, O.; Slepickova Kasalkova, N.; Kolska, Z.; Bacakova, L.; Svorcik, V. Polymer nanostructures for bioapplications induced by laser treatment. Biotechnol. Adv. 2018, 36, 839–855. [Google Scholar] [CrossRef]
- Deeksha, B.; Sadanand, V.; Hariram, N.; Rajulu, A.V. Preparation and properties of cellulose nanocomposite fabrics with in situ generated silver nanoparticles by bioreduction method. J. Bioresour. Bioprod. 2021, 6, 75–81. [Google Scholar] [CrossRef]
- Yorseng, K.; Siengchin, S.; Ashok, B.; Rajulu, A.V. Nanocomposite egg shell powder with in situ generated silver nanoparticles using inherent collagen as reducing agent. J. Bioresour. Bioprod. 2020, 5, 101–107. [Google Scholar] [CrossRef]
- Polívková, M.; Hubáček, T.; Staszek, M.; Švorčík, V.; Siegel, J. Antimicrobial Treatment of Polymeric Medical Devices by Silver Nanomaterials and Related Technology. Int. J. Mol. Sci. 2017, 18, 419. [Google Scholar] [CrossRef] [PubMed] [Green Version]
- Chaloupka, K.; Malam, Y.; Seifalian, A.M. Nanosilver as a new generation of nanoproduct in biomedical applications. Trends Biotechnol. 2010, 28, 580–588. [Google Scholar] [CrossRef] [PubMed]
- Kittler, S.; Greulich, C.; Diendorf, J.; Koöller, M.; Epple, M. Toxicity of Silver Nanoparticles Increases during Storage Because of Slow Dissolution under Release of Silver Ions. Chem. Mater. 2010, 22, 4548–4554. [Google Scholar] [CrossRef]
- Domínguez, A.; Algaba, R.A.; Canturri, A.M.; Villodres, Á.R.; Smani, Y. Antibacterial Activity of Colloidal Silver against Gram-Negative and Gram-Positive Bacteria. Antibiotics 2020, 9, 36. [Google Scholar] [CrossRef] [PubMed] [Green Version]

| Deposition Time [s] | 50 | 100 | 200 | 400 | 1000 |
|---|---|---|---|---|---|
| Surface energy [mJ·m−2] - as sputtered | 29.7 | 11.3 | 14.5 | 7.3 | 7.8 |
| Surface energy [mJ·m−2] sputtered + heat treated | 8.0 | 13.0 | 11.5 | 11.0 | 18.2 |
| Time [s] | 20 mA | 20 mA_T | 40 mA |
|---|---|---|---|
| λmax [nm] | λmax [nm] | λmax [nm] | |
| 50 s | 448 | 418 | 424 |
| 100 s | 430 | 436 | 420 |
| 200 s | 422 | 450 | 421 |
| 400 s | 432 | 447 | 406 |
| 1000 s | 432 | 437 | 456 |
Publisher’s Note: MDPI stays neutral with regard to jurisdictional claims in published maps and institutional affiliations. |
© 2022 by the authors. Licensee MDPI, Basel, Switzerland. This article is an open access article distributed under the terms and conditions of the Creative Commons Attribution (CC BY) license (https://creativecommons.org/licenses/by/4.0/).
Share and Cite
Hurtuková, K.; Vašinová, T.; Kasálková, N.S.; Fajstavr, D.; Rimpelová, S.; Pavlíčková, V.S.; Švorčík, V.; Slepička, P. Antibacterial Properties of Silver Nanoclusters with Carbon Support on Flexible Polymer. Nanomaterials 2022, 12, 2658. https://doi.org/10.3390/nano12152658
Hurtuková K, Vašinová T, Kasálková NS, Fajstavr D, Rimpelová S, Pavlíčková VS, Švorčík V, Slepička P. Antibacterial Properties of Silver Nanoclusters with Carbon Support on Flexible Polymer. Nanomaterials. 2022; 12(15):2658. https://doi.org/10.3390/nano12152658
Chicago/Turabian StyleHurtuková, Klaudia, Tereza Vašinová, Nikola Slepičková Kasálková, Dominik Fajstavr, Silvie Rimpelová, Vladimíra Svobodová Pavlíčková, Václav Švorčík, and Petr Slepička. 2022. "Antibacterial Properties of Silver Nanoclusters with Carbon Support on Flexible Polymer" Nanomaterials 12, no. 15: 2658. https://doi.org/10.3390/nano12152658
APA StyleHurtuková, K., Vašinová, T., Kasálková, N. S., Fajstavr, D., Rimpelová, S., Pavlíčková, V. S., Švorčík, V., & Slepička, P. (2022). Antibacterial Properties of Silver Nanoclusters with Carbon Support on Flexible Polymer. Nanomaterials, 12(15), 2658. https://doi.org/10.3390/nano12152658

